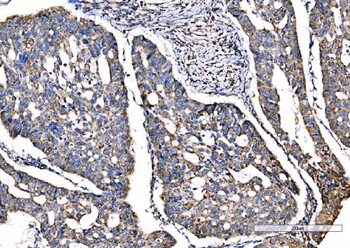
SOD2 Antibody (monoclonal, 2B12B1)

You have no items in your shopping cart.
Human SOD2 Protein
SKU: orb428541
Description
Images & Validation
−
| Application Notes |
|---|
Key Properties
−| Source | Escherichia Coli |
|---|---|
| Biological Activity | Specific activity is > 1,200 units/mg, in which one unit will inhibit the rate of reduction of cytochrome c by 50% in a coupled system, using xanthine and Xanthine oxidase at pH 7.8 at 25C in a 1.5 ml reaction volume. |
| Protein Sequence | MGSSHHHHHH SSGLVPRGSH MKHSLPDLPY DYGALEPHIN AQIMQLHHSK HHAAYVNNLN VTEEKYQEAL AKGDVTAQIA LQPALKFNGG GHINHSIFWT NLSPNGGGEP KGELLEAIKR DFGSFDKFKE KLTAASVGVQ GSGWGWLGFN KERGHLQIAA CPNQDPLQGT TGLIPLLGID VWEHAYYLQY KNVRPDYLKA IWNVINWENV TERYMACKK |
| Purity | Greater than 95% as determined by SDS-PAGE. |
Storage & Handling
−| Storage | Stability: Store at 4°C if entire vial will be used within 2-4 weeks. Store, frozen at -20°C for longer periods of time. For long term storage it is recommended to add a carrier protein (0.1% HSA or BSA).Avoid multiple freeze-thaw cycles |
|---|---|
| Form/Appearance | Sterile filtered colorless solution. |
| Buffer/Preservatives | SOD2 Human solution containing 20mM Tris-HCl pH-8 & 20% glycerol. |
| Disclaimer | For research use only |
Alternative Names
−MNSOD, MVCD6, IPOB, Mn superoxide dismutase, EC=1.15.1.1.
Similar Products
−SOD2 Antibody [orb350712]
ELISA, IF, IHC, IP, WB
Human, Mouse, Rat
Rabbit
Polyclonal
Unconjugated
50 μg, 100 μgHuman Superoxide Dismutase 2, Mitochondrial (SOD2) ELISA Kit [orb775621]
Human
0.79-50 ng/mL
0.36 ng/mL
96 T, 48 TSOD2 Antibody (monoclonal, 2B12B1) [orb1145774]
IHC, WB
Human, Mouse
Mouse
Monoclonal
Unconjugated
100 μgSOD2 Antibody [KO/KD Validated] [orb1474088]
FC, IHC, WB
Human, Mouse
Mouse
Monoclonal
Unconjugated
30 μl, 50 μl, 200 μl, 100 μl

Quality Guarantee
Explore bioreagents carefree to elevate your research. All our products are rigorously tested for performance. If a product does not perform as described on its datasheet, our scientific support team will provide expert troubleshooting, a prompt replacement, or a refund. For full details, please see our Terms & Conditions and Buying Guide. Contact us at [email protected].
Quick Database Links
Documents Download
Datasheet
Product Information
Request a Document
Protocol Information
Human SOD2 Protein (orb428541)
Based on 0 reviews
Participating in our Biorbyt product reviews program enables you to support fellow scientists by sharing your firsthand experience with our products.
Login to Submit a Review

![SOD2 Antibody [KO/KD Validated]](/images/pub/media/catalog/product/NewWebsite/16/orb1474088_1.jpg)
![SOD2 Antibody [KO/KD Validated]](/images/pub/media/catalog/product/NewWebsite/16/orb1474088_2.jpg)
![SOD2 Antibody [KO/KD Validated]](/images/pub/media/catalog/product/NewWebsite/16/orb1474088_3.jpg)
